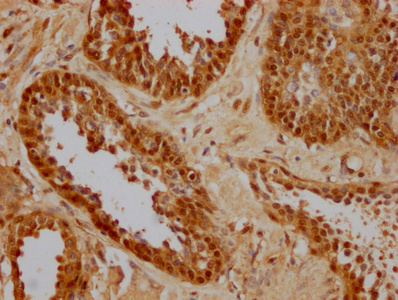

HSPA8 Monoclonal Antibody
-
中文名稱:HSPA8鼠單克隆抗體
-
貨號:CSB-MA010829A0m
-
規格:¥1320
-
圖片:
-
Western Blot
Positive WB detected in: Hela whole cell lysate, NIH/3T3 whole cell lysate, K562 whole cell lysate, HepG2 whole cell lysate, Mouse spleen tissue, Rat spleen tissue, Mouse heart tissue, Rat heart tissue
All lanes HSPA8 antibody at 1:2000
Secondary
Goat polyclonal to mouse IgG at 1/50000 dilution
Predicted band size: 70~75 KDa
Observed band size: 70~75 KDa
Exposure time: 10s -
Western Blot
Positive WB detected in: Hela whole cell lysate at 20μg, 10μg, 5μg, 2.5μg, 1.25μg, 0.625μg
All lanes: HSPA8 antibody at 1:2000
Secondary
Goat polyclonal to mouse IgG at 1/50000 dilution
Predicted band size: 70~75 KDa
Observed band size: 70~75 KDa
Exposure time: 10s -
Western Blot
Positive WB detected in: 20μg Hela whole cell lysate
HSPA8 antibody at 1:2000, 1:4000, 1:8000, 1:16000, 1:32000, 1:64000, 1:128000, 1:256000
Secondary
Goat polyclonal to mouse IgG at 1/50000 dilution
Predicted band size: 70~75 KDa
Observed band size: 70~75 KDa
Exposure time: 10s -
IHC image of CSB-MA010829A0m diluted at 1:256 and staining in paraffin-embedded human prostate cancer performed on a Leica BondTM system. After dewaxing and hydration, antigen retrieval was mediated by high pressure in a citrate buffer (pH 6.0). Section was blocked with 10% normal goat serum 30min at RT. Then primary antibody (1% BSA) was incubated at 4°C overnight, and detected by a Goat anti-mouse IgG polymer labeled by HRP and visualized using 0.05% DAB.
-
IHC image of CSB-MA010829A0m diluted at 1:256 and staining in paraffin-embedded human prostate cancer performed on a Leica BondTM system. After dewaxing and hydration, antigen retrieval was mediated by high pressure in a citrate buffer (pH 6.0). Section was blocked with 10% normal goat serum 30min at RT. Then primary antibody (1% BSA) was incubated at 4°C overnight, and detected by a Goat anti-mouse IgG polymer labeled by HRP and visualized using 0.05% DAB.
-
Immunoprecipitating HSPA8 in Hela whole cell lysate
Lane 1: Mouse control IgG2b instead of CSB-MA010829A0m in Hela whole cell lysate
Lane 2: CSB-MA010829A0m (1.5µl) + Hela whole cell lysate (500µg)
Lane 3: Hela whole cell lysate (20µg)
For western blotting, the blot was detected with CSB-MA010829A0m at 1:2000, and a HRP-conjugated Protein G antibody was used as the secondary antibody at 1:2000
. -
Overlay histogram showing MCF-7 cells stained with CSB-MA010829A0m (red line). The cells were fixed with 70% Ethylalcohol (18h) and then incubated in 10% normal goat serum to block non-specific protein-protein interactions followed by the primary antibody at 1:200 for 1 h at 4°C. The secondary antibody used was FITC goat anti-mouse IgG(H+L) at 1/100 dilution for 30min at 4°C. Isotype control antibody (green line) was mouse IgG2b used under the same conditions. Acquisition of >10,000 events was performed.
-
-
其他:
產品詳情
-
產品描述:HSPA8單克隆抗體(CUSABIO貨號:CSB-MA010829A0m)是一款針對熱休克蛋白家族成員HSPA8研發的高特異性科研試劑,該靶點作為HSP70家族核心成員,廣泛參與細胞內蛋白質折疊、轉運及應激狀態下的細胞保護機制,在神經退行性疾病、腫瘤微環境調控及細胞自噬等研究中具有重要價值。本產品采用雜交瘤技術制備,經嚴格驗證可同時識別人、大鼠、小鼠種屬的HSPA8蛋白,適用于ELISA、Western Blot、免疫組化、流式細胞術及免疫共沉淀等多種實驗體系。在腫瘤發生機制研究中,該抗體可有效檢測癌細胞中HSPA8的異常表達水平;在神經科學領域,適用于探究阿爾茨海默病等疾病模型中蛋白質錯誤折疊的分子機制;在基礎細胞生物學中,可用于追蹤應激條件下HSPA8的亞細胞定位變化。其卓越的種屬交叉反應性為跨物種比較研究提供便利,廣泛兼容常規組織樣本及細胞裂解液檢測需求,是探索蛋白質質量控制、細胞應激反應及疾病相關信號通路的可靠工具。
-
產品名稱:Mouse anti-Homo sapiens (Human) HSPA8 Monoclonal antibody
-
Uniprot No.:
-
基因名:
-
別名:2410008N15Rik antibody; Constitutive heat shock protein 70 antibody; Epididymis luminal protein 33 antibody; Epididymis secretory sperm binding protein Li 72p antibody; Heat shock 70 kDa protein 8 antibody; Heat shock 70kD protein 10 antibody; Heat shock 70kD protein 8 antibody; Heat shock 70kDa protein 8 antibody; Heat shock cognate 71 kDa protein antibody; Heat shock cognate protein 54 antibody; Heat shock cognate protein 71 kDa antibody; Heat shock protein 8 antibody; Heat shock protein A8 antibody; Heat shock protein family A (Hsp70) member 8 antibody; Heat-shock70-KD protein 10, formerly antibody; HEL 33 antibody; HEL S 72p antibody; HSC54 antibody; HSC71 antibody; Hsc73 antibody; HSP71 antibody; HSP73 antibody; HSP7C_HUMAN antibody; HSPA10 antibody; HSPA8 antibody; LAP1 antibody; Lipopolysaccharide associated protein 1 antibody; LPS associated protein 1 antibody; LPS associated protein antibody; MGC102007 antibody; MGC106514 antibody; MGC114311 antibody; MGC118485 antibody; MGC131511 antibody; MGC29929 antibody; N-myristoyltransferase inhibitor protein 71 antibody; NIP71 antibody
-
宿主:Mouse
-
反應種屬:Human, Rat, Mouse
-
免疫原:Recombinant Human Heat shock cognate 71 kDa protein (2-646AA)
-
免疫原種屬:Homo sapiens (Human)
-
標記方式:Non-conjugated
-
克隆類型:Monoclonal
-
抗體亞型:IgG2b
-
純化方式:>95%, Protein A purified
-
克隆號:2G8F6
-
濃度:It differs from different batches. Please contact us to confirm it.
-
保存緩沖液:Preservative: 0.03% Proclin 300
Constituents: 50% Glycerol, 0.01M PBS, PH 7.4 -
產品提供形式:Liquid
-
應用范圍:ELISA, WB, IHC, FC, IP
-
推薦稀釋比:
Application Recommended Dilution WB 1:10000-1:256000 IHC 1:100-1:500 FC 1:100-1:300 IP 1µl-4µl -
Protocols:
-
儲存條件:Upon receipt, store at -20°C or -80°C. Avoid repeated freeze.
-
貨期:Basically, we can dispatch the products out in 1-3 working days after receiving your orders. Delivery time maybe differs from different purchasing way or location, please kindly consult your local distributors for specific delivery time.
-
用途:For Research Use Only. Not for use in diagnostic or therapeutic procedures.
相關產品
靶點詳情
-
功能:Molecular chaperone implicated in a wide variety of cellular processes, including protection of the proteome from stress, folding and transport of newly synthesized polypeptides, activation of proteolysis of misfolded proteins and the formation and dissociation of protein complexes. Plays a pivotal role in the protein quality control system, ensuring the correct folding of proteins, the re-folding of misfolded proteins and controlling the targeting of proteins for subsequent degradation. This is achieved through cycles of ATP binding, ATP hydrolysis and ADP release, mediated by co-chaperones. The co-chaperones have been shown to not only regulate different steps of the ATPase cycle of HSP70, but they also have an individual specificity such that one co-chaperone may promote folding of a substrate while another may promote degradation. The affinity of HSP70 for polypeptides is regulated by its nucleotide bound state. In the ATP-bound form, it has a low affinity for substrate proteins. However, upon hydrolysis of the ATP to ADP, it undergoes a conformational change that increases its affinity for substrate proteins. HSP70 goes through repeated cycles of ATP hydrolysis and nucleotide exchange, which permits cycles of substrate binding and release. The HSP70-associated co-chaperones are of three types: J-domain co-chaperones HSP40s (stimulate ATPase hydrolysis by HSP70), the nucleotide exchange factors (NEF) such as BAG1/2/3 (facilitate conversion of HSP70 from the ADP-bound to the ATP-bound state thereby promoting substrate release), and the TPR domain chaperones such as HOPX and STUB1. Plays a critical role in mitochondrial import, delivers preproteins to the mitochondrial import receptor TOMM70. Acts as a repressor of transcriptional activation. Inhibits the transcriptional coactivator activity of CITED1 on Smad-mediated transcription. Component of the PRP19-CDC5L complex that forms an integral part of the spliceosome and is required for activating pre-mRNA splicing. May have a scaffolding role in the spliceosome assembly as it contacts all other components of the core complex. Binds bacterial lipopolysaccharide (LPS) and mediates LPS-induced inflammatory response, including TNF secretion by monocytes. Participates in the ER-associated degradation (ERAD) quality control pathway in conjunction with J domain-containing co-chaperones and the E3 ligase STUB1. Interacts with VGF-derived peptide TLQP-21.
-
基因功能參考文獻:
- Data suggest that both the small heat shock protein HspB1/Hsp27 and the constitutive chaperone Hsc70/HspA8 interact with tau to prevent tau-fibril/amyloid formation. Hsc70 is highly efficient at preventing tau-fibril elongation, possibly by capping ends of tau-fibrils. (HspB1 = heat shock protein family B small member 1; Hsc70 = heat shock protein family A Hsp70) PMID: 29298892
- This study demonstrated that particular distribution for HSC70 and PSMC4 in the cytoplasm and accumulation within Lewy body in the dopaminergic neurons of the substantia nigra in Parkinson patients. PMID: 29218503
- Hsp70participated in PINK1-mediated mitophagy by stabilizing PINK1. PMID: 29107085
- These results demonstrate not only an important mechanism of Hsc70 in facilitating EV-A71 replication, but also a target for antiviral drug development. PMID: 29180285
- Post-transcriptional inhibition of HSPA8 expression leads to synaptic vesicle cycling defects in multiple models of amyotrophic lateral sclerosis. PMID: 28978466
- Taken together, these data suggest hat the altered hydrogen bonding observed in the Hsc70 C17W mutant (where the connectivity between Mg2+.nucleotide and E175 is also disrupted) could bring about changes to Hsc70 domain communication, affecting peptide association while also limiting ATP hydrolysis. PMID: 29300467
- The roles of the E3 ubiquitin ligase, carboxy-terminus Hsc70 interacting protein (CHIP) in various types of cancers. PMID: 28731191
- Hsc70/Hsp90 chaperones contribute to the conformational and functional maintenance of DeltaF508-CFTR at 37 degrees C. PMID: 28855508
- Engagement of the oligomer by LAP1 triggers ATP hydrolysis and rapid complex disassembly. Thus the Torsin complex is a highly dynamic assembly whose oligomeric state is tightly controlled by distinctively localized cellular cofactors. PMID: 28814508
- Downregulation of Hsc70, Hsp70, and IL-15 expression at gene and/or protein levels might support the retention of fertilization products in cases of missed abortion and blighted ovum. PMID: 27225940
- STRO-1 binds to immune-precipitated HSC70 and siRNA-mediated knock down of HSPA8 reduced STRO-1 binding. PMID: 28026090
- Synapsin is part of a multiprotein complex enriched in chaperones/cochaperones including Hsc70. Hsc70 chaperone activity is required for the cytosolic slow axonal transport of synapsin. PMID: 28559423
- study demonstrates a critical role of Hsc70 in SV40 endoplasmic reticulum-to-cytosol penetration and reveal how SGTA controls Hsc70 to impact this process PMID: 28356524
- In fact, DnaJC5 overexpression induced tau release in cells, neurons, and brain tissue, but only when activity of the chaperone Hsc70 was intact and when tau was able to associate with this chaperone. PMID: 27261198
- These results suggest that Bag1 and Bag3 control the stability of the Hsc70-client complex using at least two distinct protein-protein contacts, providing a previously under-appreciated layer of molecular regulation in the human Hsc70 system. PMID: 27474739
- While cerebrospinal fluid Nrf2 and HSPA8 do not appear to offer diagnostic biomarkers for Parkinson's disease (PD), the associations between Nrf2 levels and UPDRS scores in LRRK2 + PD patients merit further investigation PMID: 26526034
- HSPA8 maintains pluripotency of human pluripotent stem cells by binding to the master pluripotency regulator OCT4 and facilitating its DNA-binding activity. PMID: 26549849
- heat shock cognate 70 (HSC70) is an essential component of Aes foci in colorectal cancer cells. PMID: 26229111
- Cx43-Hsc70 interaction regulates cell cycle G1/S progression through a novel mechanism by which Cx43-Hsc70 interaction prevents the nuclear accumulation of p27 through controlling the nuclear translocation of cyclin D1-CDK4-p27 complex. PMID: 26481195
- serum HSC71 was identified as a novel serum biomarker of renal cell carcinoma, particularly useful in early diagnosis of clear-cell type. PMID: 26425554
- These findings provide further evidence that histatin 3 may be involved in the regulation of cell proliferation, particularly during G1/S transition, via the ubiquitin-proteasome system of p27(Kip1) and HSC70. PMID: 26775844
- constitutive heat shock protein HSC70 forms granule-like structures in the cytoplasm of human cells several days after the exposure to heat stress PMID: 26335814
- These results indicate that CHIP decreases the Kv1.5 protein level and functional channel by facilitating its degradation in concert with chaperone Hsc70 PMID: 26232501
- Active Hsc70 requires active tau to regulate microtubule assembly in vivo, suggesting that tau acts in some ways as a co-chaperone for Hsc70 to coordinate microtubule assembly. PMID: 25882706
- detailed and systematic investigation to characterize if there are significant differences in the CHIP in vitro ubiquitination of human Hsp70 and Hsc70. PMID: 26010904
- HSP70 binds CD91 and TLR4 on decidual CD1a(+) dendritic cells, causes their maturation, and increases IL-15 in the context of Th1 cytokine/chemokine domination, which could support immune response harmful for ongoing pregnancy. PMID: 25737151
- LAP1 mutations are associated with severe dystonia, cerebellar atrophy and cardiomyopathy. PMID: 26596547
- HSC70 may serve as a molecular switch to modulate endocytic and autophagy pathways, impacting the source of antigens delivered for MHC class II presentation during cellular stress. (Review) PMID: 25953005
- CHIP docks onto Hsp70/Hsc70 and defines a bipartite mode of interaction between TPR domains and their binding partners. PMID: 25684577
- Hsc70 interacted with Rab1A in a chaperone-dependent mannerand Hsc70 knockdown decreased the level of Rab1A and increased the level of its ubiquitination under stress conditions. PMID: 24801886
- Data suggest that nhibition of nestin and heat shock protein HSPA8/HSC71 may be a useful molecular target in the treatment of glioblastomas. PMID: 25527454
- LAP1 and LULL1 regulate Torsin ATPase activity through an active site complementation mechanism. PMID: 25352667
- H-ERG trafficking was impaired by H2O2 after 48 h treatment, accompanied by reciprocal changes of expression between miR-17-5p seed miRNAs and several chaperones (Hsp70, Hsc70, CANX, and Golga20) PMID: 24386440
- the endogenous DNAJC12 and Hsc70 proteins interact in LNCaP cells. PMID: 24122553
- Endoplasmic reticulum-associated degradation of Niemann-Pick C1: evidence for the role of heat shock proteins and identification of lysine residues that accept ubiquitin. PMID: 24891511
- Results identify a systemic hsc70 reduction in Parkinson's disease patients. PMID: 24361989
- Hsp73 sustains Hsp90 chaperone function and critically contributes to cell survival in multiple myeloma patients. PMID: 23065523
- These findings indicate that wild type ILK and the non-oncogenic ILK(R211A) mutation comprise a cardioprotective module with Hsp/c70. PMID: 24260102
- A significant downregulation of HSPA8 and HSPA9 was observed in AD across the three brain regions compared to the controls, suggesting their participation in AD pathogenesis. PMID: 23948933
- HSP8A polymorphism is associated with drug-naive schizophrenia. PMID: 24548631
- Cx43-Hsc70 interaction probably plays a critical role during G1/S progression. PMID: 24056538
- These results demonstrate that Hsp70 recruits PP5 and activates its phosphatase activity which suggests dual roles for PP5 that might link chaperone systems with signaling pathways in cancer and development. PMID: 24327656
- Altered expression of Hsc70 and eIF5A-1 may cause defects in nucleocytoplasmic transport and play a role in esophageal carcinogenesis. PMID: 23539416
- the U-box mutation stimulated CHIP binding to Hsc70 while promoting CHIP oligomerization. CHIP binding to Hsc70 binding was also stimulated by the presence of an Hsc70 client with a preference for the ADP-bound state. PMID: 23990462
- GLIPR1 interacts with Hsc70, and GLIPR1 overexpression or Hsc70 knockdown leads to transcriptional suppression of AURKA and TPX2. PMID: 23333597
- PKCiota knockdown sensitized cells to oxidative stress-induced apoptosis, whereas forced PKCiota expression counteracted the oxidative stress-induced apoptosis via Hsc70. PMID: 23224638
- Relaxation-based NMR experiments on the Hsc70-CHIP complex determined that the two partners move independently in solution, similar to "beads on a string PMID: 23865999
- LAP1 and LULL1 as regulatory cofactors that are responsible for the activation of TorA's ATPase activity. PMID: 23569223
- 70-kDa heat shock cognate protein hsc70 mediates calmodulin-dependent nuclear import of the sex-determining factor SRY. PMID: 23235156
- Studies suggest that Hsc70 and lysosome-associated protein 2A (LAMP-2A) through chaperone-mediated autophagy (CMA) play a role in the clearance of Htt and suggest a novel strategy to target the degradation of mutant huntingtin (Htt). PMID: 23071649
顯示更多
收起更多
-
亞細胞定位:Cytoplasm. Melanosome. Nucleus, nucleolus. Cell membrane. Note=Localized in cytoplasmic mRNP granules containing untranslated mRNAs. Translocates rapidly from the cytoplasm to the nuclei, and especially to the nucleoli, upon heat shock.
-
蛋白家族:Heat shock protein 70 family
-
組織特異性:Ubiquitous.
-
數據庫鏈接:
Most popular with customers
-
-
YWHAB Recombinant Monoclonal Antibody
Applications: ELISA, WB, IHC, IF, FC
Species Reactivity: Human, Mouse, Rat
-
Phospho-YAP1 (S127) Recombinant Monoclonal Antibody
Applications: ELISA, WB, IHC
Species Reactivity: Human
-
-
-
-
-